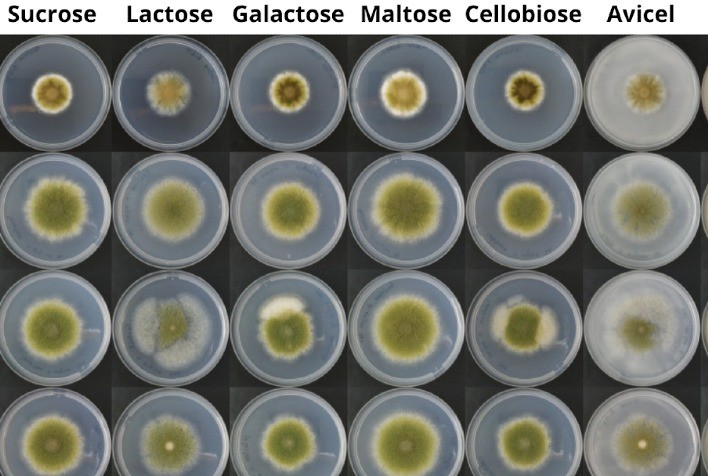
Fungos ganham espaço como fonte de proteína sustentável e alternativa à carne

Fungos ganham espaço como fonte de proteína sustentável e alternativa à carne
Avanços em engenharia genética e fermentação de precisão impulsionam a produção de micoproteínas como alternativa à carne, mas desafios técnicos, nutricionais e regulatórios ainda precisam ser superados
Publicado em: 13/10/2025 às 16:00hs
Micoproteínas: o futuro das proteínas sustentáveis
Pesquisas recentes em engenharia genética e fermentação de precisão estão transformando os fungos em uma fonte promissora de proteínas, conhecidas como micoproteínas. Derivadas do micélio — a estrutura de sustentação dos fungos — essas proteínas oferecem alto valor nutricional, textura semelhante à carne e menor impacto ambiental.
O mercado global de micoproteínas deve ultrapassar US$ 32 bilhões até 2032, impulsionado pelo interesse crescente em alternativas à carne convencional.
Fungos como fábricas celulares
Segundo André Damasio, pesquisador da Unicamp, os avanços em biotecnologia têm transformado fungos filamentosos e leveduras em fábricas celulares capazes de produzir proteínas recombinantes de leite, ovos e carne, com menor impacto ambiental.
Empresas como Meati, Quorn e Enough já produzem em escala industrial, utilizando modelos B2B e promovendo mudanças no setor alimentício.
"A produção de micoproteínas exige menos terra e água, e emite menos gases de efeito estufa do que a pecuária convencional. Esse sistema pode mitigar os impactos ambientais da agricultura intensiva", explica Damasio.
Desafios técnicos, nutricionais e regulatórios
Apesar do potencial, micoproteínas ainda enfrentam barreiras. O alto teor de fibras do micélio e sua composição nutricional distinta exigem ajustes em textura, sabor e funcionalidade para uso em diversos produtos alimentícios.
Para Gabriel Mascarin, engenheiro agrônomo da Embrapa Meio Ambiente, há também desafios de segurança alimentar e regulamentação. Estudos sobre biodisponibilidade de aminoácidos, efeitos à saúde e controle de toxinas e metais pesados são fundamentais.
A aplicação de biologia sintética e tecnologias “ômicas” tem acelerado o desenvolvimento de linhagens mais produtivas e resistentes, enquanto a edição genética precisa permite superar gargalos na produção industrial.
Micoproteínas como complemento à dieta
Para Paula Cunha, pesquisadora da Unicamp, o objetivo não é substituir a carne, mas oferecer alternativas acessíveis e sustentáveis, diversificando a dieta e reduzindo o impacto ambiental.
Ao integrar micoproteínas às cadeias alimentares, é possível fortalecer a segurança alimentar e aumentar a resiliência dos sistemas agroindustriais frente às mudanças climáticas e à pressão sobre recursos naturais.
Investimentos e mercado em expansão
Nos últimos cinco anos, a fermentação de biomassa fúngica recebeu € 628 milhões em investimentos, superando a carne cultivada (€ 459 milhões). Produtos como os da Quorn, Meati e Eternal apresentam 45-48% de proteínas e 22-35% de fibras, sabor neutro e textura próxima à carne.
O cultivo de micélio também se destaca por baixa emissão de CO₂, pegada hídrica reduzida e uso de subprodutos agrícolas como substratos.
O mercado global de análogos de carne com micélio está avaliado em US$ 7,2 bilhões, com crescimento anual de 10,78% até 2032, enquanto substitutos de laticínios podem atingir US$ 32,38 bilhões, crescendo 13,85% ao ano.

Benefícios nutricionais e limitações
Micoproteínas fornecem aminoácidos essenciais e minerais como zinco e selênio, podendo auxiliar na redução do colesterol, controle da glicemia e síntese de proteína muscular.
No entanto, ainda não contêm vitamina B12 nem ferro, e estudos sobre digestibilidade e potencial alergênico são necessários, especialmente diante de reações observadas em consumidores de produtos Quorn.
Além disso, produtos à base de micoproteínas são considerados “novos alimentos”, exigindo rigorosas avaliações de segurança antes da comercialização, e não são recomendados para crianças menores de três anos.
Empresas líderes e inovação
Empresas como Quorn, Meati e The Better Meat Co. estão à frente na produção escalável e versátil de micoproteínas, oferecendo produtos que vão desde linguiças até carnes vegetais secas, muitas vezes combinadas com proteínas vegetais e microalgas para enriquecer valor nutricional.
Se os desafios técnicos, regulatórios e de aceitação do consumidor forem superados, os fungos podem se tornar peça-chave na construção de um sistema alimentar mais sustentável, nutritivo e inclusivo.
Fonte: Portal do Agronegócio
◄ Leia outras notícias